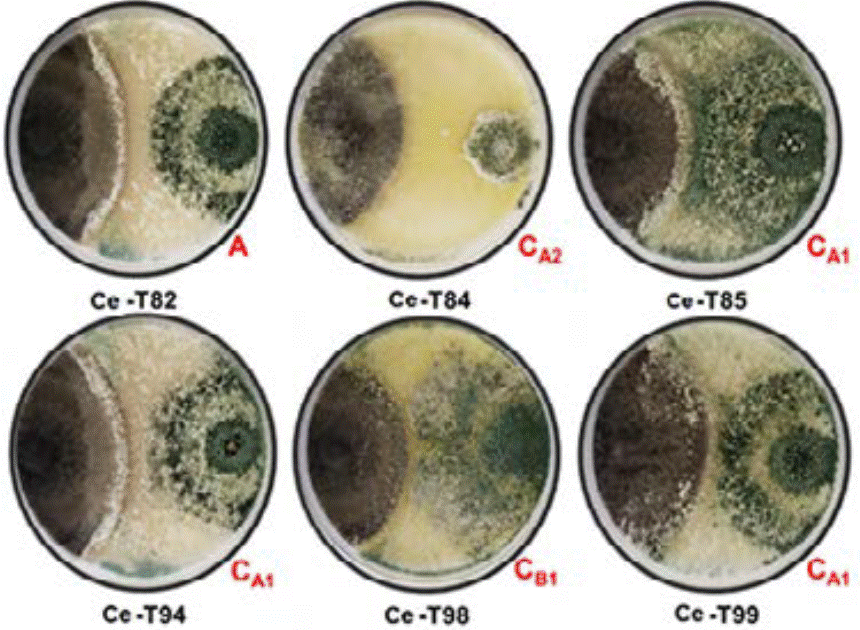
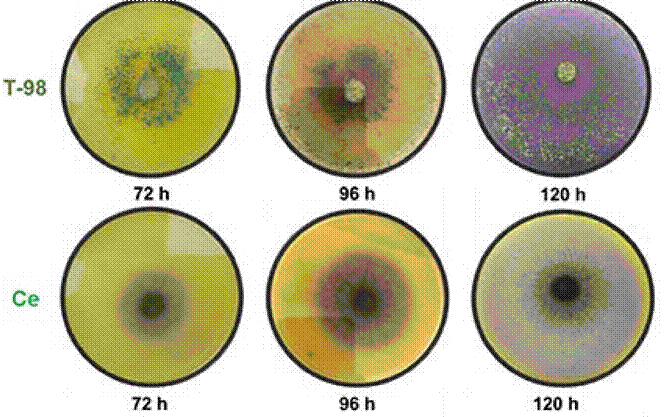

Introducción
La Mancha Foliar (MF) de la piña (Ananas comosus L.) causada por Curvularia eragrostidis (Henn.) J.A. Mey, es una enfermedad fúngica, común en diversos países productores como México (García-Ordaz et al. 2021). El desarrollo de infecciones causadas por especies de Curvularia en piña, incluyen lesiones irregulares rodeadas de halos amarillos, cloróticos o necróticos, visibles en las hojas (Ferreira et al. 2014, Zhong et al. 2016). Algunos estudios revelan que especies de Curvularia excretan moléculas orgánicas capaces de generar daño necrótico en diferentes órganos de las plantas (Liu et al. 2009).
Para el manejo integrado de la MF, algunos esfuerzos en la búsqueda de compuestos con actividad biológica contra C. eragrostidis se han basado en el estudio de extractos vegetales de Swietenia humilis Zucc., como control biorracional (Maldonado-Michel et al. 2021). Por otro lado, para el control cultural, se ha implementado la labranza del suelo, uso de láminas de riego adecuadas, desinfección de herramientas y uso de acolchados plásticos (Rebolledo-Martínez et al. 2005). Sin embargo, el empleo de agentes químicos sintéticos tales como tebuconazol, propiconazol, carbendazim y metalaxil, han sido la principal estrategia de control (Bahekar et al. 2017, García-Ordaz et al. 2021).
La búsqueda de agentes de control biológico microbiano (MBCAs por sus siglas en inglés) nativas y adaptadas a las regiones locales de producción, es una actividad que puede ayudar a reducir el uso de fungicidas sintéticos y tóxicos en la producción de frutales (Köhl et al. 2019). El uso de MBCAs se ha intentado para combatir enfermedades fungosas en piña, como es el caso de las especies de Trichoderma, que ha demostrado actividad antagonista in vitro sobre Phytophthora nicotianae, Rhizoctonia solani y Fusarium subglutinans (Hernández-Mansilla et al. 2006, Sabando-Ávila et al. 2017). El género Trichoderma Pers., es considerado un MBCA por excelencia, que actúa contra hongos fitopatógenos a través de micoparasitismo y competencia por nutrientes y espacio, produciendo una amplia gama de metabolitos especializados, tales como antibióticos y moléculas que inactivan enzimas del patógeno y que son capaces de detener los procesos infecciosos (Martínez et al. 2013). Asimismo, Trichoderma posee gran cantidad de enzimas hidrolíticas como quitinasas y ß-glucanasas, ampliamente estudiadas por su capacidad para degradar polímeros que constituyen la pared celular de la mayoría de los hongos fitopatógenos (Di Cologna et al. 2017, Bae et al. 2017). Adicionalmente, se ha demostrado que, durante cultivos antagónicos, Trichoderma tiene la capacidad de producir in situ peróxido de hidrógeno (H2O2), que es un oxidante y un precursor de radicales libres, que participa en los procesos de oxidación avanzada (Chan-Cupul et al. 2016). El género Trichoderma se comporta como saprófito, endófito y patógeno de otros hongos, incluyendo a especies de Curvularia (Ramírez-Olier et al. 2019), por lo que resulta un antagónico natural candidato para el desarrollo de productos biológicos para tratar casos de MF causada por C. eragrostidis. Sin embargo, no se han reportado especies de Trichoderma nativas que hayan sido estudiadas para el manejo de C. eragrostidis causante de la MF en la producción de piña en México.
En este trabajo, probamos la capacidad antagónica de diversas cepas nativas de Trichoderma sobre una cepa de C. eragrostidis aislada del cultivo de piña afectado con MF en el estado de Colima, junto a la capacidad antagónica, se estudió el efecto de la presencia de peróxido de hidrógeno (H2O2) y actividad enzimática ligninolítica (lacasa) e hidrolítica (quitinasa y ß-glucanasa) para profundizar en la interacción de ambas especies.
Materiales y métodos
Aislamiento del fitopatógeno
Se realizaron visitas de campo en plantaciones de Ananas comosus (var. “MD2”) en el rancho “El Milagro” ubicado en la localidad de Cerrito de Aguilar, municipio de Tecomán, Colima (18°47´41” N y 103°51´26.9” O) y se colectaron plantas con síntomas de la MF. Para el aislamiento, el tejido vegetal se lavó y desinfestó con hipoclorito de sodio (1 %) durante 10 min y se enjuagó con agua destilada estéril. El tejido seco y desinfestado se separó en hojas verdes y secas, posteriormente las hojas verdes se colocaron en un mortero y se les adicionó nitrógeno líquido y se trituraron, hasta obtener un polvo fino (Doyle, 1991). El proceso se repitió con las hojas secas y todas las muestras obtenidas se liofilizaron. Se colocó 0.1 g de muestra liofilizada en matraces con 120 mL de medio de cultivo Czapek, las muestras se incubaron a 27±2 °C a 150 rpm, durante 48 h en una incubadora (LabTech, E.U.A.). Con el caldo de cultivo se realizó un estriado en cajas de Petri con agar dextrosa papa (PDA, MCD Lab, Tlalnepantla, Edo. de México), las cajas de Petri se incubaron a 30±2 °C (temperatura ambiente). Siete días después, una vez que los micelios esporularon, se realizó una purificación a través de resiembras en cajas de Petri con PDA en condiciones de laboratorio en cámara de incubación (25.0±3.0, 75 % de humedad relativa y 12/12 h luz/oscuridad) de acuerdo con la metodología de Maldonado-Michel et al. (2021).
Identificación morfológica, molecular y postulados de Koch de C. eragrostidis
La identificación morfológica y molecular del aislado de C. eragrostidis, así como los postulados de Koch en plantas de piña fueron reportados por Maldonado-Michel et al. (2021).
Reactivación de cepas de Trichoderma
Las cepas nativas de varias especies de Trichoderma., aisladas de suelo arenoso, en el municipio de Tecomán, Colima y resguardados en la Facultad de Ciencias Biológicas y Agropecuarias de la Universidad de Colima, se reactivaron en cajas Petri con PDA. En total fueron reactivadas seis cepas nativas, las cajas de Petri se incubaron y mantuvieron en condiciones de laboratorio hasta su uso.
Interacciones entre Trichoderma spp. - C. eragrostidis
Las confrontaciones se realizaron a nivel macroscópico. Se tomaron discos de agar-micelio (6 mm de θ) de C. eragrostidis de siete días de edad (dde) y se depositaron en cajas de Petri con medio de cultivo PDA a 1 cm del borde izquierdo de la caja. Veinticuatro horas después se depositaron los discos de agar-micelio (6 mm de θ) de Trichoderma spp. en los lados opuestos, se utilizaron seis repeticiones por tratamiento y se incubaron a 25±3 °C por seis días (Badalyan et al. 2002). El porcentaje de inhibición de crecimiento (% IC) de cada fitopatógeno se calculó con la siguiente fórmula:
Donde: A1= área de crecimiento del patógeno sobre el lado opuesto, evaluada en la caja Petri y A2= área de crecimiento del patógeno en enfrentamiento. Las áreas respectivas se determinaron con el software ImageJ (National Institute of Health, Maryland, E.U.A.). Además, se determinaron los tipos de interacciones interespecíficas en los cultivos duales siguiendo la metodología propuesta por Badalyan et al. (2004), que consistió en una escala de valoración visual con tres tipos (A, B y C) y cuatro subtipos (CA1, CB1, CA2 y CB2) para cada hongo, donde: A= bloqueo al contacto, en la cual ninguno de los microorganismos es capaz de sobrecrecer al otro después del contacto con su micelio; B= bloqueo a distancia, sin contacto entre ambos micelios; C= reemplazo, sobrecrecimiento sin bloqueo inicial; CA1= reemplazo parcial después de bloqueo inicial; CA2= reemplazo total después de bloqueo inicial; CB1= reemplazo parcial después de bloqueo inicial a distancia; CB2= reemplazo total después de bloqueo inicial a distancia. De acuerdo con Badalyan et al. (2002), cada uno de los tipos y de los subtipos de interacción tienen un valor asignado de: A = 1, B = 2, C = 3, CA1 = 3.5, CB1 = 4, CA2 = 4.5, CB2 = 5. Con los valores se calculó el índice de antagonismo (IA) para cada cepa utilizada (Badalyan et al. 2002) a través de la siguiente fórmula:
Dónde n=número (frecuencia) de cada tipo o subtipo de interacción.
Extracto enzimático
Para la cuantificación de lacasa, H2O2 y proteína total, se preparó el extracto enzimático a partir de diez discos con agar-micelio (6 mm de θ) de cada una de las cajas Petri provenientes de la confrontación. En cada repetición se tomaron diez discos micelio-agar y se colocaron en un tubo Falcon (25 mL) con 10 mL de agua destilada estéril. Los tubos se dejaron en agitación en una incubadora-rotatoria (Lab-Line Instruments, Inc. Modelo: 3530, Melrose Park, E.U.A.) a 150 rpm durante 24 h, después la solución resultante fue filtrada en papel filtro (Whatman No. 1) con una bomba de vacío. Al final el filtrado resultante se utilizó para determinar el contenido de lacasa, peróxido de hidrógeno (H2O2) y proteína total (Chan-Cupul et al. 2019).
Cuantificación de lacasa
Se empleó el método descrito por Sunil et al. (2011), por medio de la oxidación de ABTS [ácido 2,2’-azino-bis (3-etilbenzotiazolina-6-sulfónico)] (Sigma-Aldrich, E.U.A.). El volumen total de la mezcla de reacción fue de 1 mL, se le agregaron 700 µL de extracto enzimático, 200 µL de buffer acetato de sodio (0.1 M, pH 4.5) y 100 µL de ABTS (0.05 mM). La oxidación del sustrato se monitoreó 420 nm por tres minutos en un espectrofotómetro (Luzeren, LS6, E.U.A.), una mezcla de reacción sin ABTS fue empleada como blanco. Una unidad de actividad enzimática de lacasa fue definida como la cantidad de la lacasa que oxida 1 µmol de sustrato (ABTS) por minuto. Las actividades de lacasa fueron expresadas como unidad de actividad específica (U/mg de proteína).
Cuantificación de H2O2
Se determinó por el método de yoduro/yodato, según Klassen et al. (1994). Se mezclaron 3 mL de solución A [33 g de Kl, 1 g de NaOH, 0.1 g de (NH4)6Mo7O24•4H2O] en 500 mL de agua destilada en 3 mL de solución B [10 g de KHP] en 500 mL de agua destilada y 3 mL de extracto enzimático. La reacción se leyó a 351 nm en un espectrofotómetro, el blanco se estableció sustituyendo el extracto enzimático con agua destilada estéril, en la mezcla de reacción. El contenido de peróxido de hidrógeno se calculó en una curva estándar con concentraciones conocidas de H2O2 grado analítico (30 %, Sigma-Aldrich, E.U.A.).
Proteína total
El contenido de proteína total en el extracto enzimático se realizó por el método de Bradford (1976). El reactivo de Bradford se preparó mezclando 5 mg de azul de Coomassie G-250, 2.5 mL de etanol (grado analítico), 5 mL de ácido fosfórico y 50 mL de agua destilada estéril. La mezcla de reacción consistió en 1 mL del extracto enzimático y 1 mL del reactivo de Bradford, la reacción se midió a 595 nm en espectrofotómetro. Se empleó albúmina de huevo como estándar a concentraciones conocidas en una curva estándar para determinar la concentración de proteína total en mg/mL de las muestras de estudio.
Actividad de quitinasa y ß-glucanasa
La producción de quitinasa se determinó a través de un ensayo cualitativo con la cepa Trichoderma sp. T-98 y con C. eragrostidis, la cepa de Trichoderma para este bioensayo fue seleccionada por presentar los porcentajes de inhibición más altos contra C. eragrostidis. Se utilizó un medio basal sólido con la siguiente composición (por litro): 0.3 g de MgSO47H2O, 3 g de (NH4)2SO4, 2 g de KH2PO4, 1 g de ácido cítrico monohidratado, 18 g de agar, 200 μL de Tween 80, 4.5 g de quitina de caparazón de camarón (Sigma-Aldrich, E.U.A.) y 0.15 g de púrpura de bromocresol (Sigma-Aldrich, E.U.A.).
Una vez mezclados todos los componentes, el pH del medio se ajustó a 4.7 con ácido cítrico y después se esterilizó a 121 °C durante 18 min (1.8 psi). Se inoculó un disco de agar-micelio (6 mm de θ) de las cepas en cajas de Petri con medio basal sólido, dichas cajas se incubaron durante 3 días a 30 °C y se observó la formación de halos de color púrpura, lo cual es indicativo de actividad quitinasa (Karimi et al. 2017; Sharma et al. 2017).
Para el ensayo cualitativo de ß-glucanasa, la determinación se realizó en medio de cultivo sólido siguiendo la metodología de Karimi et al. (2017) con ligeras modificaciones. Se utilizó medio de cultivo Czapeck agar suplementado con el 1 % de carboximetil-celulosa (CMC, Sigma-Aldrich, E.U.A.). Una vez solidificado el medio, se inoculó un disco con micelio activo de la cepa Trichoderma sp. T-98 y C. eragrostidis al centro de la caja Petri. Éstas se incubaron a 30 °C durante 3 días. La actividad enzimática sobre las cajas se observó por inmersión en colorante Yodo de Gram (2 g de KI y 1 g de yodo en 300 mL de agua destilada) durante 20 min, seguido por desteñido con 1 N de NaCl y después con 1 N de NaOH durante 15 min. La actividad glucanasa se registró como el área de aclaramiento sobre el medio de cultivo.
Análisis de datos
Los datos de actividad de lacasa, producción de H2O2 y proteína total, se analizaron a través de la prueba de t-Student para determinar si existe diferencia significativa entre el monocultivo de C. eragrostidis y su cultivo dual con seis cepas de Trichoerma spp. Mientras que para la discriminación entre las cepas de Trichoderma spp. se realizó un análisis de varianza y una comparación de medias (Tukey, P≤0.05). Todos los análisis se efectuaron con StatGraphics® y Prism® para Windows®.
Resultados
Identificación morfológica y molecular de C. eragrostidis
El hongo en PDA formó micelios lanosos con un color inicial de blanco a café oscuro, mientras que, a partir de los 8 dde continúa cambiando de grisáceo a color pardo oliváceo o negro. En su micromorfología los micelios presentan hifas septadas de color pardo, con conidióforos simples o ramificados y curvados, el tamaño de los conidios es de 8-14 × 21-35 µm (Figura 1). La identificación molecular de la cepa concordó con Curvularia eragrostidis (Hennings) (J.A. Meyer) con una similitud del 99.8 % con los números de registro: MH938080.1 y LT715562.1 en la base de datos GenBank (Maldonado-Michel et al. 2021), las secuencias de la cepa de estudio se depositaron en el GenBank con número de acceso MZ510930.
Interacciones de Trichoderma spp. - C. eragrostidis
Trichoderma sp. T-98 inhibió el crecimiento de C. eragrostidis en 61.66 %, este valor fue significativamente mayor (P=0.00001) al resto de las cepas evaluadas, las cuales oscilaron entre 41.73 % (T-99) y 56.51 % (T-85) como se muestra en la Tabla 1. Las interacciones resultantes de los co-cultivos entre Trichoderma spp. y C. eragrostidis se presentan en la Tabla 2 y Figura 2. Trichoderma sp. T-84 presentó el mayor IA (4.5) con una interacción del tipo reemplazo completo después de una inhibición al contacto (CA2). La cepa Trichoderma sp. T-98 presentó un IA de 4.0 con una interacción del tipo reemplazo parcial después de una inhibición a distancia (CB1). Las cepas Trichoderma sp. T-85, T-94 y T-99 presentaron un IA de 3.5 con un reemplazo parcial después de una inhibición al contacto. Finalmente, Trichoderma sp. T-82 presentó un IA más bajo (1), con una inhibición al contacto (Figura 2).
Tabla 1 Porcentaje de inhibición en el crecimiento de C. eragrostidis a siete días de interacción con cepas de Trichoderma spp.
| Cepa de Trichoderma spp. | Inhibición (%) |
| T-82 | 50.57±0.17 e |
| T-84 | 55.14±0.51 c |
| T-85 | 56.51±0.19 b |
| T-94 | 53.69±0.26 d |
| T-98 | 61.66±0.11 a |
| T-99 | 41.73±0.16 f |
| F= | 603.57 |
| P-Valor= | 0.00001 |
Medias con diferente literal son significativamente diferentes entre sí (Tukey test, P≤0.05).
Tabla 2 Índice de antagonismo entre C. eragrostidis a siete días de interacción con cepas de Trichoderma spp. según la escala de Badalyan et al. (2004)
| Trichoderma spp. | Interacción | IA |
| T-82 | A | 1 |
| T-84 | CA2 | 4.5 |
| T-85 | CA1 | 3.5 |
| T-94 | CA1 | 3.5 |
| T-98 | CB1 | 4 |
| T-99 | CA1 | 3.5 |
| IA Total | 20 |
IA= índice de antagonismo
Figura 2 Tipos de interacciones entre C. eragrostidis (Ce) y cepas de Trichoderma spp. Ce-T82) A= inhibición al contacto. Ce-T84) CA2= reemplazo completo después de una inhibición al contacto. Ce-T85) CA1= reemplazo parcial después de una inhibición al contacto. Ce-T94) CA1= reemplazo parcial después de una inhibición al contacto. Ce-T98) CB1= reemplazo parcial después de una inhibición a distancia. Ce-T99) CA1= reemplazo parcial después de una inhibición al contacto.
Actividades enzimáticas de C. eragrostidis en co-cultivo con Trichoderma spp.
Lacasa. La actividad específica de la lacasa se vio incrementada en los co-cultivos de C. eragrostidis con cepas de Trichoderma spp. los valores oscilaron entre 0.219 y 0.076 U/mg de proteína, mientras que en monocultivo de C. eragrostidis se registró un valor de 0.027 U/mg de proteína. El co-cultivo con la cepa Trichoderma sp. T-94 obtuvo el valor más alto, resultando 7.11 veces mayor al monocultivo, pero estadísticamente igual entre las otras cepas de Trichoderma spp. (F= 2.59, P-Valor= 0.0402, Tabla 3).
Tabla 3 Características bioquímicas de C. eragrostidis en interacción con cepas de Trichoderma spp.
| Tratamientos | Lacasa | H2O2 | Proteína |
| (U/mg de proteína) | (mg/L) | (mg/L) | |
| C. eragrostidis | 0.027±0.004 b | 0.33±0.04 d | 11.33±0.20 cd |
| Ce-T-82 | 0.102±0.02 ab | 1.28±0.13 c | 10.96±1.18 d |
| Ce-T-84 | 0.103±0.01 ab | 4.38±0.50 b | 15.88±0.62 bc |
| Ce-T-85 | 0.076±0.01 ab | 1.21±0.12 c | 16.21±1.73 b |
| Ce-T-94 | 0.219±0.07 a | 0.74±0.21 cd | 8.94±2.26 d |
| Ce-T-98 | 0.089±0.03 ab | 6.47±0.34 a | 22.86±2.53 a |
| Ce-T-99 | 0.104±0.03 ab | 0.86±0.11 cd | 16.13±1.19 b |
| F= | 2.59 | 79.65 | 8.56 |
| P-Valor= | 0.0402 | 0.00001 | 0.00001 |
Medias en columnas con diferente literal son significativamente diferentes entre sí (Tukey test, P≤0.05). U es la cantidad de la lacasa que oxida 1 μmol de ABTS por minuto. Ce = C. eragrostidis, T = Trichoderma spp.
Producción de peróxido de hidrógeno. Se incrementó la producción de H2O2 en los co-cultivos entre C. eragrostidis y Trichoderma spp. en comparación con el monocultivo de C. eragrostidis (F= 79.65, P-Valor=0.00001, Tabla 3). El co-cultivo entre Trichoderma sp.-T98 y C. eragrostidis presentó la mayor producción de H2O2 con 6.47 mg/mL, a comparación del resto de las interacciones (0.74 mg/mL en C. eragrostidis-Trichoderma sp. T-94 y 4.8 mg/mL en C. eragrostidis-Trichoderma sp. T-84) y el monocultivo de C. eragrostidis (0.33 mg/mL).
Proteína total. La proteína total incrementó significativamente en el co-cultivo C. eragrostidis-Trichoderma sp. T-98 con un valor de 22.86 mg/mL, resultando mayor al monocultivo de C. eragrostidis (11.33 mg/L) y al resto de las interacciones, las cuales presentaron valores en un intervalo de 8.94 (C. eragrostidis-Trichoderma sp. T-94) a 16.21 mg/mL (C. eragrostidis-Trichoderma sp. T-85, Tabla 3).
Ensayo cualitativo de quitinasa. En la medición cualitativa de la actividad de quitinasa producida por las cepas T-98 y C. eragrostidis, se observó la formación de halos de color púrpura, lo cual es indicativo positivo de actividad de quitinasa en ambas cepas. La cepa de Trichoderma sp. T-98, no mostró ninguna presencia de halos color púrpura hastas las 72 h, mientras que a las 96 h sí se observó la coloracion púrpura en la caja Petri, y a las 120 h toda la caja Petri presentó coloracion púrpura. Por su parte, C. eragrostidis presentó en todo momento la formacion de los halos púrpuras conforme se desarrolló en el medio (Figura 3).
Figura 3 Actividad enzimática cualitativa de quitinasa de las cepas Trichoderma sp.,T-98 y C. eragrostidis, Ce.
Ensayo cualitativo de ß-glucanasa. Para la cepa Trichoderma sp. T-98 se consideró positiva para la producción de ß-glucanasa al mostrar la formación de halos de aclareamiento alrededor del micelio. Por el contrario, para C. eragrostidis se consideró negativa la actividad ya que no formó halos de aclareamiento (Figura 4).
Discusión
Las cepas de Trichoderma spp. poseen la habilidad de inhibir y desplazar a C. eragrostidis, al mismo tiempo, la confrontación de estos microorganismos incrementa la producción de H2O2 y actividad de lacasa. Asimismo, los dos hongos presentan cualitativamente actividad de quitinasa y ß-glucanasa. La especie de C. eragrostidis ya ha sido reportada con anterioridad como agente causal de la MF en el cultivo de piña, así como también como agente causal de la podredumbre postcosecha del fruto (Ferreira et al. 2014).
Los resultados obtenidos indican que las cepas estudiadas de Trichoderma poseen la habilidad para inhibir y desplazar a C. eragrostidis, esto coincide con Bahekar et al. (2017) quienes reportaron la eficacia in vitro de agentes de control sobre Curvularia lunata aislada de sábila (Aloe vera), se encontró que T. harzianum tiene una eficacia del 65.35 % de inhibición, valor similar al encontrado con Trichoderma sp. T-98 (61.66 %) contra C. eragrostidis aislada de piña (A. comosus).
En otro estudio, Tekade et al. (2017) evaluaron el efecto de diferentes agentes bioactivos como Trichoderma viride, T. harzianum, contra Curvularia lunata, aislada de coléo (Solenostemon blumei); dónde, T. viride registró una inhibición del 60.81 %, seguido de T. harzianum con 50.71 %. Mientras que, Sunpapao et al. (2018) reportaron a T. harzianum TM2/1, y una cepa endofítica de Trichoderma V76-12, para el control de la MF causada por Curvularia oryzae en hojas de palma de aceite (Elaeis guineensis Jacq.), dónde el aislado endofítico de Trichoderma V76-12 inhibió el crecimiento de C. oryzae en 85.71 %, seguido del aislado T. harzianum TM2/1 con 75.71 %. Por lo tanto, se demuestra que Trichoderma spp. resultó eficiente como agente bioactivo contra especies de Curvularia.
Las interacciones resultantes de los co-cultivos entre C. eragrostidis y Trichoderma spp. que más frecuencia se obtuvo fue el remplazo parcial después de una inhibición al contacto (CA1), inhibición al contacto (A), reemplazo completo después de una inhibición al contacto (CA2), las cuales coinciden con las interacciones encontradas por Badalyan et al. (2004), quienes también reportaron repetidamente estos tipos de interacciones en las confrontaciones de tres especies de Trichoderma (T. viride, T. harzianum y T. pseudokoningii) con distintos hongos xilotróficos. Asimismo, Chan-Cupul et al. (2019) reportaron, que las interacciones resultantes entre la confrontación de Trichoderma sp. (SP6) y los hongos de la pudrición blanca (Pycnoporus sanguineus y Trametes maxima) corresponden con inhibición al contacto (CA1) y reemplazo total después de bloqueo inicial a distancia (CB2), lo que nos sugiere que Trichoderma generalmente produce un reemplazo parcial después de una inhibición al contacto, por lo tanto, esta característica es importante, al momento de seleccionar cepas para el control biológico de C. eragrostidis en cultivos de importancia económica como lo es la piña.
La capacidad de especies de Curvularia para producir lacasa ha sido estudiada por distintos autores. Al respecto, Banerjee y Vohra (1991) reportaron la habilidad de una cepa de Curvularia sp. nativa de suelo para producir 0.75 U/L de actividad (volumétrica) lacasa; Neoh et al. (2014) reportaron una actividad volumétrica de 30 U/L de lacasa en C. clavata; Patel y Bhaskaran (2016) reportaron la capacidad de C. aeria (25.4 U/mL), C. akaii (18.1 U/mL) y C. lunata (166.2 U/mL) para producir lacasa en fermentación líquida (actividad volumétrica). Las lacasas producidas por Curvularia están involucradas en una variedad de funciones fisiológicas como la deslignificación, la morfogénesis y el parasitismo. Se ha demostrado que las lacasas y otras enzimas como la beta-glucosidasa producidas por cepas fitopatógenas de C. lunata son las responsables de la degradación de la barberina, una sustancia presente en el follaje de las plantas, durante la patogénesis (Yilmaz et al. 2022). Por otro lado, la producción de lacasas y otros compuestos antimicrobianos (filtrados) por cepas no fitopatógenas de C. lunata han demostrado efectividad en la inhibición del crecimiento de hongos fitopatógenos como Botrytis cinerea (48%), Fusarium oxysporum (18 %) y Rhizoctonia solani (80%), demostrando así, el rol de esta enzima en la defensa contra otros hongos en bioensayos de confrontación (Komeil y Saad 2021). Para el caso de las interacciones entre Trichoderma spp. y C. eragrostidis pudiera ser que los incrementos en la actividad lacasa, también estén involucrados en los mecanismos de defensa, ya que se ha demostrado que Trichoderma viride incrementa su actividad de lacasa en presencia de una variedad de microorganismos, incluyendo bacterias y otros hongos (Lakshmanan y Sadasivan 2016). Por otra parte, la producción de H2O2 en una especie de Curvularia ya ha sido reportada con antelación por Van-Schijndel et al. (1994), quienes documentaron la presencia de H2O2 en la producción de cloroperoxidasas de vanadio por Curvularia inaequalis. Sin embargo, no existen evidencias de la producción de H2O2 por especies de Curvularia spp. en sistemas de co-cultivo, por lo tanto, se describe por primera ocasión el incremento de H2O2 en cultivos duales entre Trichoderma spp. y C. eragrostidis.
En lo que respecta a la producción de quitinasas y ß-glucanasas, se tienen reportes por parte de Trichoderma sp. (Di Cologna et al. 2017; Bae et al. 2017), esto se comprobó con la cepa de Trichoderma T-98, al inducir la producción de quitinasas y ß-glucanasas sobre medios de cultivo sólidos suplementados con quitina de caparazón de camarón y carboximetil-celulosa, respectivamente. Para Curvularia sp., Soares et al. (2006) estudiaron la producción cualitativa de quitinasas por C. eragrostidis mediante la producción de halos en el medio sólido. En cuanto ß-glucanasas, solo existen datos cuantitativos de la capacidad de Curvularia sp. para su producción (Okunowo et al. 2010), esto se puede deber a que la producción de ß-glucanasas por parte de Curvularia sp. no se puede apreciar en la prueba cualitativa, lo que coincidiría con lo obtenido en esta investigación.
Los resultados obtenidos podrían tener diversas aplicaciones, como el control biológico de C. eragrostidis en el cultivo de la piña empleando las cepas Trichoderma sp. T-84 y T98 como posibles agentes biocontroladores, debido a que presentaron el mayor índice de antagonismo y mayor porcentaje de inhibición, respectivamente. Sin embargo, para ello es necesario establecer un protocolo de producción de esporas de Trichoderma sp. T-84 y T98, en fermentación en estado sólido y la evaluación de la efectividad de ambas cepas tanto in vivo como in situ. En este tenor, Ramírez-Olier et al. (2019) evaluaron antagonismo in vitro de T. asperellum contra C. lunata, donde obtuvieron parasitismo grado cuatro con porcentaje mayor al 90 % de inhibición. En C. eragrostidis se ha reportado inhibiciones arriba del 80 % y reemplazos totales en co-cultivos con Trichoderma sp. (Tenorio et al. 2019).
Otra aplicación relacionada con las lacasas producidas por Curvularia spp. en monocultivo o en interacción con Trichoderma spp., es en el mejoramiento de la calidad nutritiva de fuentes fibrosas para su empleo en la alimentación animal, al respecto, Vazquez et al. (2020) produjeron lacasas en co-cultivos entre C. kusanoi y especies de Trichoderma (T. viride y T. pleuroticola) en fermentación sólida en salvado de trigo (Triticum aestivum) y evaluaron la capacidad degradativa de las lacasas para la deslignificación de la paja cruda de trigo y digestibilidad in vitro del bagazo de caña (Saccharum officinarum), como resultado los autores indicaron que el tratamiento de la paja cruda de trigo y bagazo de caña a través de las lacasas, mejoraron su calidad nutricional al disminuir los componentes fibrosos e incrementaron su digestibilidad in vitro.
Conclusiones
Las cepas de Trichoderma spp. inhibieron el crecimiento de C. eragrostidis, la cepa con mayor porcentaje de inhibición Trichoderma sp. T-98 y presentó un reemplazo parcial después de una inhibición a distancia. La mayoría de las cepas presentaron un reemplazo parcial después de una inhibición al contacto. C. eragrostidis produjo actividad lacasa e incrementó al interactuar con Trichoderma sp. T-94 en al menos 7.1 veces más. C. eragrostidis también produjo H2O2 e incrementó su producción como resultado de la confrontación con Trichoderma sp. T-98 en al menos 18.6 veces más. Trichoderma sp. T-98 produjo cualitativamente quitinasas y ß-glucanasas; mientras que, C. eragrostidis solo fue capaz de producir quitinasas.











 nova página do texto(beta)
nova página do texto(beta)





